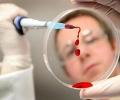
����������� � �������� �������� ������ � ��������� ������ �����

Согласно сообщению пресс-службы ГУ МВД России по
Пермскому краю, вчера около девяти часов вечера в дежурную часть отдела МВД РФ «Березниковский»
обратилась пожилая местная ...

Как сообщается в пресс-релизе МВД России, в Москве
удалось пресечь деятельность банды мошенников, которые торговали биологически
активными добавками. По предварительным данным сумма ущерба от ...

В пресс-службе ГУ МВД по ЦФО рассказали, что
следователям удалось выйти на след банды, напавшей в конце 2012 года на одного
из жителей столицы. ...

В ночь на 22 февраля на центральной магистрали Москвы -
Кутузовском проспекте произошло очередное ДТП с участием автомобиля с номерами
серии АМР, принадлежащего госструктурам. ...

В следственном комитете Саратова возбуждено
уголовное дело по факту избиения полицейскими одного из местных жителей. Инцидент
произошел в дежурной части отдела полиции, куда пострадавшего ...

На автозаправочной станции в Сургуте, расположенной
на улице Базовая произошел взрыв. По предварительной версии ЧП произошло из-за
разгерметизации баллона с газом автомобиля, находящегося на ...

Как
стало известно из оперативных источников, водитель машины марки ВАЗ-2106,
будучи в состоянии сильного алкогольного опьянения, на большой скорости
протаранил жилой дом в местном ...

Как сообщают РИА Новости, хабаровские врачи диагностировали
у школьника, вернувшегося из Таиланда, свиной ...

Представитель Морского государственного университета имени
Невельского во Владивостоке сообщил в четверг, 21 февраля, о том, что декан этого
высшего российского учебного заведения утонул в ...

Представитель СУ СК РФ по Приморскому краю сообщает в
четверг, 21 февраля, о том, что пять рабочих из КНДР погибли на одной из строек
...
Страницы:
в начало |
1510 |
1511 |
1512 |
1513 |
1514 |
1515 |
в конец

19.08.2023 11:29 → AFROJACK LENDER → We offer private, commercial and personal loans at...
21.07.2023 15:05 → Armani Escort → In the event that you are in or close to Frankfurt...
07.06.2016 08:51 → Сергей → Мы теряем драгоценнейшее время. Ну когда это касае...
04.06.2016 05:48 → Ксения → Ужас какой и так у нас мужчин мало...
02.06.2016 18:42 → Татьяна → Без Разина и так понятно кто такая Лера, стоит пос...
23.05.2016 15:12 → бомж → хорошо ,что дети не сгорели....
20.05.2016 08:29 → Елена → Заметила, с каким пренебрежением журналисты пишут ...
30.04.2016 16:36 → Алексей → Федорович все ещё гражданин Украины!!!! Песков: гр...
29.04.2016 11:49 → Ягоза → Если это горел газопровод то вероятнее всего в рай...